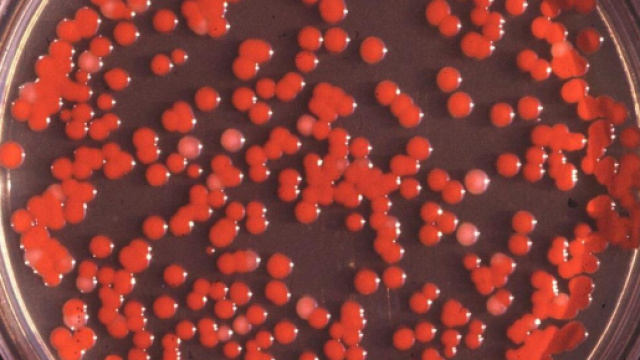
Una coltura di Serratia marcescens.

Si chiama Serratia marcescens il batterio che ha causato la morte di un neonato ricoverato presso gli Spedali civili di Brescia, che ha contagiato altri bimbi. Si tratta di un Gram negativo appartenente alla famiglia degli enterobatteri. Ne esistono diverse specie tra cui la liquefaciens che si riscontra più raramente, ma sempre in ambito ospedaliero.
Per quanto concerne la marcescens, il suo nome deriva dal fatto che il batterio, dopo aver prodotto la prodigiosina, un pigmento dal colore rosso acceso, marcisce trasformandosi in una massa fluida mucillaginosa.
È nota negli ambienti nosocomiali da decenni, ma ultimamente, secondo quanto riportato dagli esperti di Microbiologia Italia, sta acquisendo maggior pericolosità data la sua accresciuta resistenza agli antibiotici. Negli ospedali di tutto il mondo, infatti, si stanno sviluppando pericolosi focolai d'infezione e risulta molto difficoltoso combattere il batterio con gli antibiotici di cui attualmente si dispone.
Responsabile delle infezioni ospedaliere
Stando ai risultati di un monitoraggio e di un test di sorveglianza condotti in Usa e in Europa, sembra che la Serratia marcescens sia la responsabile del 6,5% di tutte le infezioni da Gram negativi contratte in terapia intensiva, e del 3,5% delle infezioni in pazienti che non si trovano in terapia intensiva.
Inoltre viene classificata come settima causa di polmonite, e decima per quanto riguarda le infezioni del flusso sanguigno.
Un alto fattore di rischio è rappresentato dal catetere urinario, che può favorire il rischio di contagio da Serratia. Anche tubi e sonde, introdotte per le vie aeree, possono generare infezioni dell'apparato respiratorio e, più raramente, del cuore. La diffusione principale, ad ogni modo, si verifica al contatto con il personale ospedaliero e, per questo motivo, i vari istituti sanitari stanno approntando misure di controllo e di contenimento per evitare epidemie. Solo un anno fa, ad esempio, l'unità di terapia intensiva neonatale dell'Ospedale La Paz di Madrid era stata chiusa dal ministero della Salute spagnolo dopo il contagio di 51 bambini.
Neonati e malati in pericolo
Il caso del neonato deceduto qualche giorno fa presso gli Spedali Civili di Brescia, ha spinto la procura bresciana ad aprire un'indagine condotta dai carabinieri dei Nas. Il bimbo morto ha un gemello, anche lui contagiato dal batterio, così come altri piccoli pazienti. Al momento, per fortuna, nessuno di loro è in pericolo di vita, come hanno dichiarato i medici della struttura sanitaria di Brescia.
Allo stesso tempo, però, è stato sottolineato come siano aumentati i rischi per la salute in seguito al contagio, poiché questi batteri stanno sviluppando una certa resistenza agli antibiotici: ad oggi, infatti, le infezioni ospedaliere hanno causano la morte di settemila persone ogni anno, contagiandone 500mila.
È necessario, dunque, che le misure di sorveglianza e di contenimento dei batteri nosocomiali siano rafforzate per evitare lo sviluppo di focolai sempre più difficili da gestire anche a causa della resistenza batterica. L'ospedale di Brescia, in un comunicato ufficiale ha dichiarato che il microrganismo incriminato è stato identificato ed isolato il 20 luglio tramite emocolture, e dopo aver riscontrato in alcuni neonati i sintomi della congiuntivite in seguito a dei tamponi oculari. Due dei tre bambini colpiti in forma grave dall'infezione sono migliorati con la terapia antibiotica, mentre purtroppo il terzo ha sviluppato segni clinici da shock settico che hanno peggiorato il suo quadro clinico, portandolo al decesso il 6 agosto.